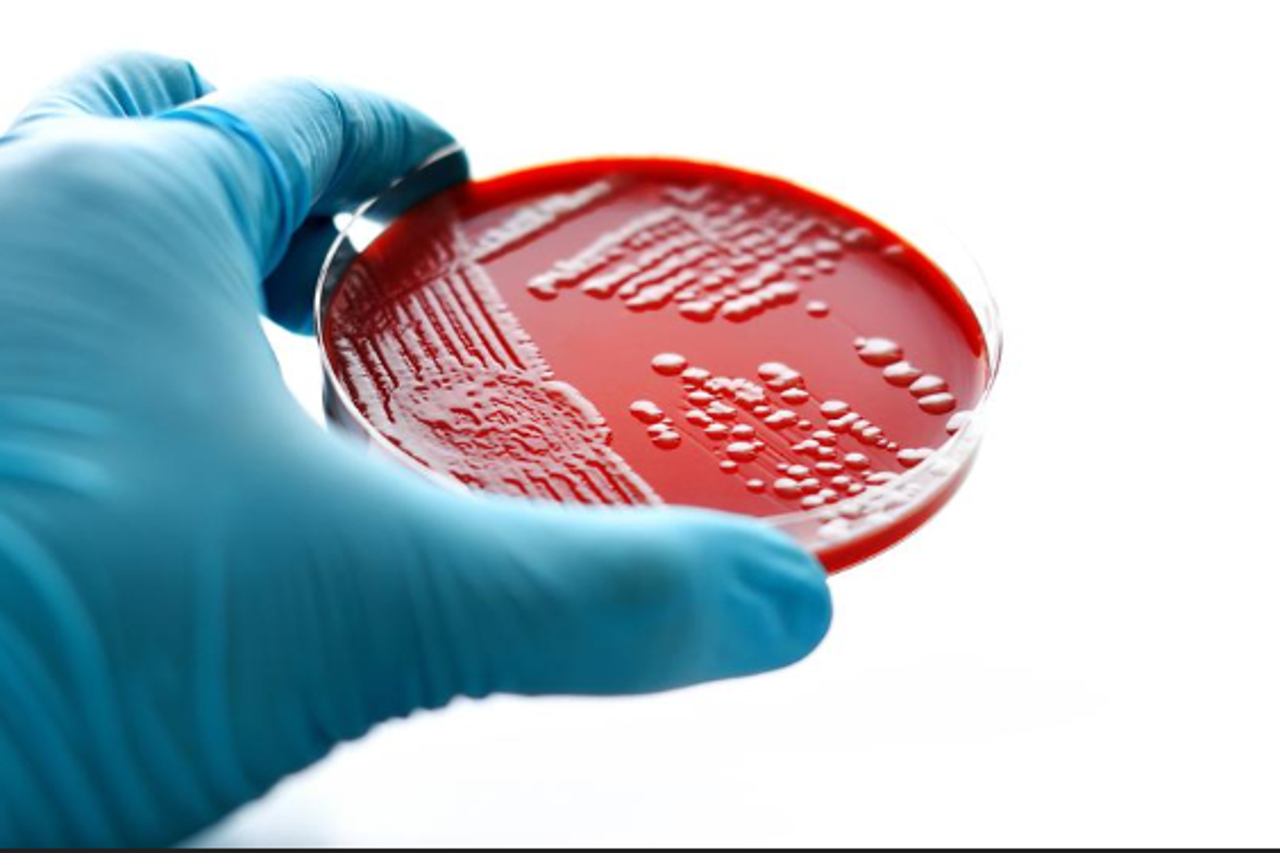

potiče se recikliranje
EU uvodi zabranu uništavanja neprodane odjeće i obuće
Procjenjuje se da se svake godine u Europi 4 do 9 posto neprodanih tekstilnih proizvoda uništi prije no što ih se ikad odjene.